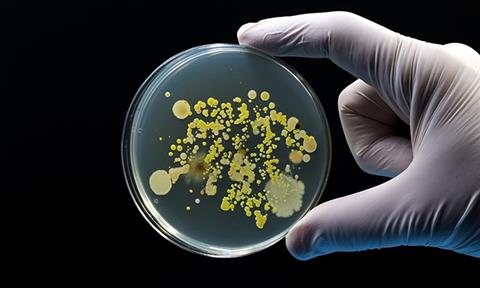
shutterstock_2238868725

The AMR Multi-Stakeholder Partnership Platform has developed key recommendations for action on antimicrobial resistance for consideration by UN Member States.
Antimicrobial resistance (AMR) is one of the top global public health and development threats. According to the World Health Organization (WHO), an estimated 4.95 million deaths were associated with antimicrobial resistance in 2019, including 1.27 million deaths attributable to bacterial AMR. Limiting the emergence and spread of resistant pathogens is critical to preserving the world’s ability to treat human, animal and plant diseases, reduce food safety and security risks and maintain progress on the WHO's sustainable development goals.
The AMR Multi-Stakeholder Partnership Platform has developed key recommendations for action on antimicrobial resistance for consideration by United Nations (UN) Member States in the UN General Assembly High-Level Meeting on AMR, which will take place on 26 September 2024 at the UN Headquarters in New York, US.
The following key recommendations are based on discussions facilitated by the Action Group of the AMR Multi-Stakeholder Partnership Platform on the UN High-Level Meeting on AMR. The stakeholders of the platform, representing diverse sectors (human, animal, agrifood, plant, environment), disciplines and backgrounds, are calling upon the UN Member States to agree upon actionable, measurable steps applying a One Health approach to ensure a healthier, more sustainable and resilient present and future where antimicrobials are preserved as critical life-saving medicines, equally accessible to everyone, everywhere.
- Enhance One Health collaboration on AMR through effective cross-sectoral, transparent, inclusive, multilateral, multidisciplinary, multi-stakeholder coordination, communication and follow-through
- Accelerate the implementation of AMR National Action Plans (NAPs), building on country context, capacity and capabilities
- Strengthen capacity for AMR efforts by mobilising sustainable financing for research, infrastructure and AMR NAPs implementation
- Strengthen health systems through comprehensive primary and secondary prevention strategies, such as infection prevention and control (IPC), stewardship programmes, water, sanitation and hygiene (WASH), vaccination, early diagnosis and prompt treatment and environmental management of air, water, soil, food and vectors for better human, animal and environmental health
- Better leverage preventive measures such as vaccination by expanding the evidence base on their impact against AMR, developing mechanisms to increase access and utilisation of existing vaccines, improving regulatory pathways, facilitating market authorisation and distributing products across sectors and countries
- Strengthen sector-specific AMR and antimicrobial use (AMU) surveillance, building towards integrated surveillance for evidence-based action to reduce the risk and impact of AMR
- Transform agrifood systems to significantly reduce AMU while optimising animal health and welfare
- Ensure universal, equitable, affordable and sustainable access, including in rural areas, to quality essential medicines, vaccines and diagnostics for humans and animals
- Encourage high-income countries and other stakeholders to commit to taking an end-to-end approach to sustainable antimicrobial research and development (R&D), including by increasing public investment in push and pull incentives to catalyse the global R&D efforts necessary to deliver new treatments and tools that target global priority pathogens
- Prevent and address the drivers, sources and challenges of the environmental dimensions of AMR.
The AMR Multi-Stakeholder Partnership Platform was established in November 2022 by the Quadripartite organisations - the Food and Agriculture Organisation of the United Nations (FAO), the United Nations Environment Programme (UNEP), the World Health Organisation (WHO) and the World Organisation for Animal Health (WOAH) - as one of the global governance structures recommended by the United Nations Inter-Agency Coordination Group on AMR.
It brings together relevant stakeholders across the human, animal, plant and environment sectors to assist in preserving antimicrobials and ensuring their responsible use through a One Health approach. It promotes a shared global vision, helps build consensus and takes action to contribute to the implementation of the Global Action Plan on AMR (GAP). Since its inaugural meeting in November 2023, the platform has grown to more than 200 members (organisations, networks and federations).
Read the full recommendations (and their brief version), watch the public release event and join the AMR Multi-Stakeholder Partnership Platform's global movement for action against AMR.


